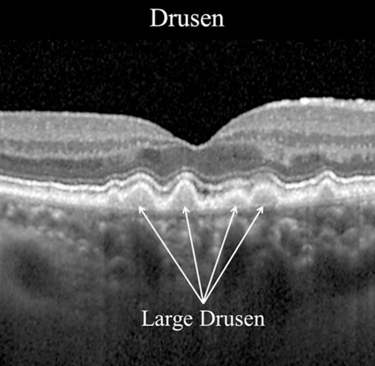

Understanding Age-Related Macular Degeneration (AMD)


Many patients hear the word macular degeneration and immediately think: “I’m going blind.”
This is one of the biggest misunderstandings.
According to the American Academy of Ophthalmology (AAO), age-related macular degeneration affects the macula — the small, central part of the retina responsible for sharp, detailed vision.
The macula allows you to:
read small text
recognize faces
see fine details
drive safely
AMD affects this central zone. It does not usually take away side (peripheral) vision.
There are two main types
- Dry AMD (more common)
Dry AMD develops slowly. The retina shows small deposits called drusen. Vision may gradually become less sharp over years. Many patients live with mild dry AMD for a long time without major disability.
There is currently no injection treatment for dry AMD, but lifestyle factors matter:
Stop smoking
Maintain cardiovascular health
Follow a Mediterranean-style diet
In certain stages, specific AREDS2 vitamin supplements may reduce progression risk (AAO-supported evidence)
- Wet AMD (less common, more aggressive)
Wet AMD happens when abnormal blood vessels grow under the macula and leak fluid or blood.
Symptoms can appear suddenly:
Straight lines look wavy
A dark or blurry central spot
Rapid vision distortion
This form is considered urgent.
The good news?
Modern anti-VEGF injections have dramatically improved outcomes.
In many cases, vision can be stabilized — and sometimes even improved — if treatment starts early.
When should you seek care urgently?
According to AAO guidance:
If you notice:
sudden distortion of lines
rapid central blur
a new dark spot in your central vision
you should contact an eye doctor promptly.
Not every change means wet AMD. But wet AMD should never wait.
What AMD does not mean
It does not mean:
total blindness
immediate vision loss
loss of independence
Many patients continue reading, working, and driving for years with proper monitoring.
A calm but realistic perspective
AMD is common. It is age-related. It is manageable.
The key is awareness — not fear.
If you are over 50 and notice subtle central changes, ask for an eye examination.
A simple retinal scan can often clarify the situation quickly.
Understanding reduces anxiety.
And early care protects vision.

Bernani - Clear Eye Guidance
Privacy Policy | Terms of Use | Affiliate Disclosure
© 2026. All rights reserved.
